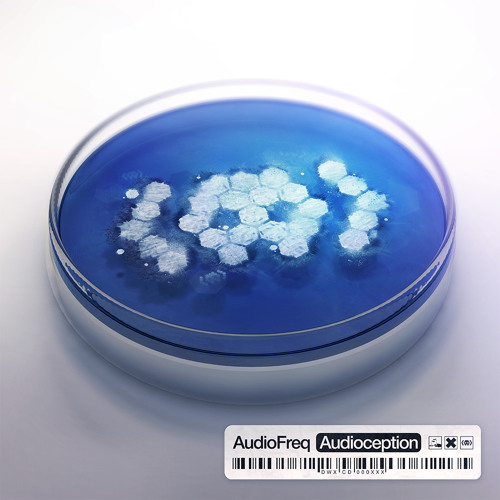
Audiofreq ft. MC Shureshock - Speekaz Kikk (Official HQ Preview)

Official preview of Audiofreq ft. MC Shureshock - Speekaz Kikk
Release date: October 2013
An "Audioception" preview.
Follow Audiofreq
Facebook: www.facebook.com/audiofreqdj
Twitter: twitter.com/#!/audiofreqDJ
Website: …
Complete lyrics are now on Lololyrics :) www.lololyrics.com/…
awesome!!
Huuge!!
